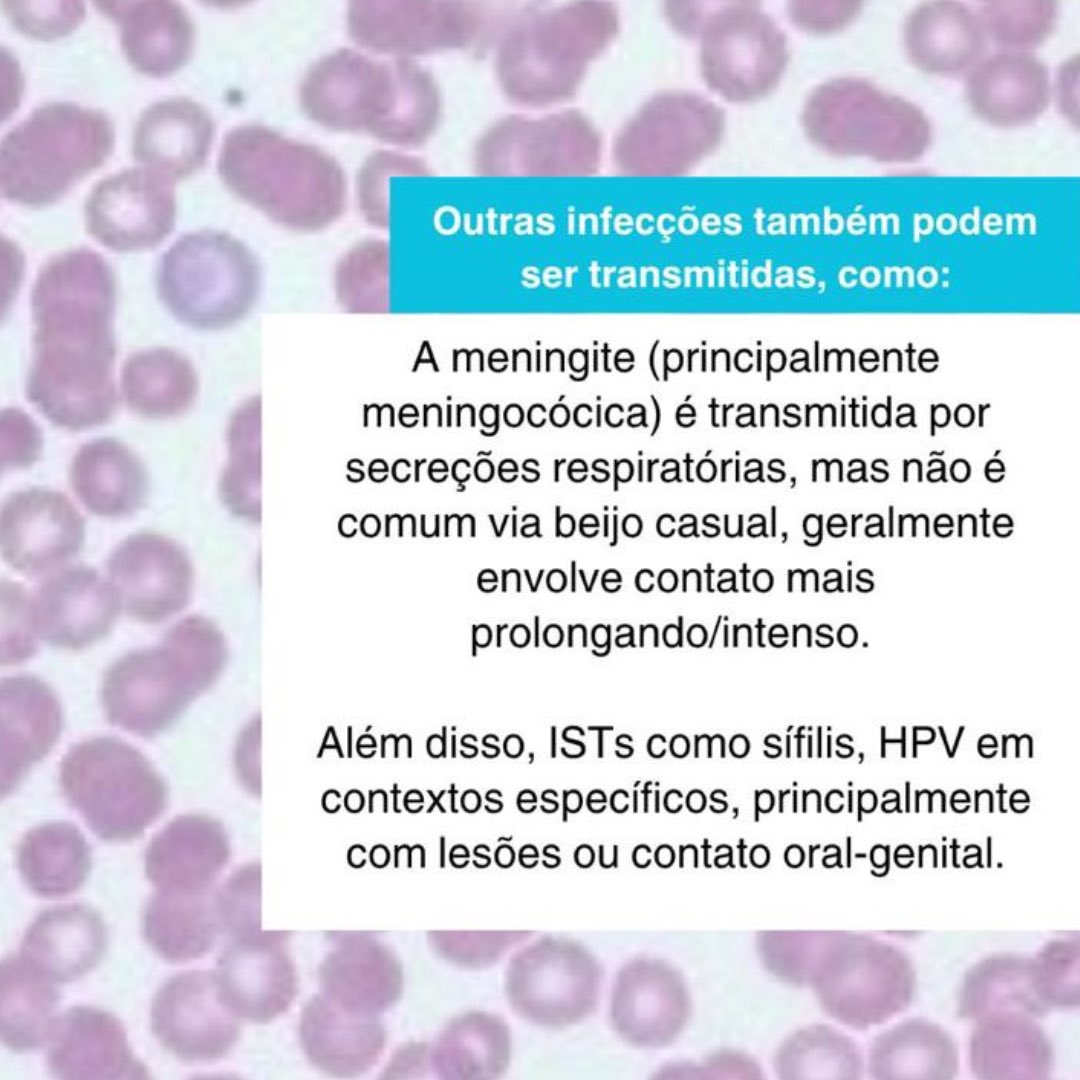
Amanda Meirelles tweet media

Sabitlenmiş Tweet

Papo Saúde com Avène Brasil 🤍🧡
por Amanda Meirelles
Proteção Solar e Prevenção contra o Câncer de Pele
Episódio Completo
@draameirelles conversa com Dr Elimar Gomes sobre prevenção, identificação e tratamento desse câncer.
youtube.com/watch?v=YfydcB…

YouTube
Português